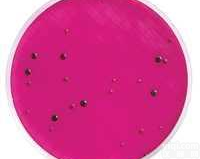
结晶紫中性红<em>胆盐</em><em>琼脂</em>（含<em>葡萄糖</em>和乳糖）

2.强烈建议您不要将琼脂糖粉末直接倒入沸水中,这样做会引起爆沸,溅出,致使浓度下降,还会造成结块而融化困难。正确的做法是称量一定量琼脂糖至三角瓶中,根据配制浓度加入一定量的缓冲液(与电泳缓冲液一致),加盖硅胶塞(防止温度差别造成表面结膜),微波或其他方式加热至沸腾2分钟左右,戴手套小心取出,摇匀,使之完全溶解。
(1)MS培养基 它是1962年由Murashige和Skoog为培养烟草细胞而设计的。特点是无机盐和离子浓度较高,为较稳定的平衡溶液。其养分的数量和比例较合适,可满足植物的营养和生理需要。它的硝酸盐含量较其他培养基为高,广泛地用于植物的器官、花药、细胞和原生质体培养,效果良好。有些培养基是由它演变而来的。
(2)B5培养基 是1968年由Gamborg等为培养大豆根细胞而设计的。其主要特点是含有较低的铵,这可能对不少培养物的生长有YZ作用。从实践得知有些植物在B5培养基上生长更适宜,如双子叶植物特别是木本植物。
(3)White培养基 是1943年由White为培养番茄根尖而设计的。1963年又作了改良,称作White改良培养基,提高了MgSO4的浓度和增加了鹏素。其特点是无机盐数量较低,适于生根培养。
(4)N6培养基 是1974年朱至清等为水稻等禾谷类作物花药培养而设计的。其特点是成分较简单,KNO3和(NH4)2SO4含量高。在国内已广泛应用于小麦、水稻及其他植物的花药培养和其他组织培养。
小鼠解整合素样金属蛋白酶9(ADAM9)elisa试剂盒 Mouse A Disintegrin And Metalloprotease 9,ADAM9 ELISA试剂盒 96T/48T
小鼠氧化型谷胱甘肽(GSGS)elisa试剂盒 Mouse oxidizided glutathione,GSGS ELISA试剂盒96T/48T
小鼠还原型谷胱甘肽(GSH)elisa试剂盒 Mouse reduced glutathione,GSH ELISA试剂盒96T/48T
小鼠肌钙蛋白T(Tn-T)elisa试剂盒 Mouse Troponin T,Tn-T ELISA试剂盒96T/48T
小鼠c-fos elisa试剂盒 Mouse c-fos ELISA试剂盒 96T/48T
小鼠c-jun elisa试剂盒 Mouse c-jun ELISA试剂盒 96T/48T
小鼠抗透明带抗体(aZP)elisa试剂盒 Mouse anti-zona pellucida antibody,aZP ELISA试剂盒96T/48T
小鼠粘蛋白/粘液素7(MUC7)elisa试剂盒 Mouse Mucin-7,MUC7 ELISA试剂盒96T/48T
小鼠嗜酸性粒细胞阳离子蛋白(ECP)elisa试剂盒 Mouse eosinophil cationic protein,ECP ELISA试剂盒 96T/48T
小鼠Qa淋巴细胞抗原2(Qa-2)elisa试剂盒 Mouse Qa lymphocyte antigen 2 region,Qa-2 ELISA试剂盒96T/48T
小鼠D-乳酸脱氢酶(D-LDH)elisa试剂盒 Mouse D-Lactate Dehydrogenase,D-LDH ELISA试剂盒 96T/48T
小鼠孕酮受体(PROGR)elisa试剂盒 Rat Progesterone receptor,PROGR ELISA试剂盒96T/48T
小鼠胰岛素样生长因子结合蛋白6(IGFBP-6)elisa试剂盒 Mouse Insulin-like growth factor binding protein 6,IGFBP-6 ELISA试剂盒 96T/48T
小鼠肺部活化调节趋化因子(PARC/CCL18)elisa试剂盒 Mouse pulmonary activation regulated chemokine,PARC ELISA试剂盒96T/48T
小鼠溶菌酶(LZM)elisa试剂盒 Mouse Lysozyme,LZM ELISA试剂盒 96T/48T
小鼠β连环蛋白/联蛋白(β-Cat)elisa试剂盒 Mouse β-catenin,β-cat ELISA试剂盒96T/48T
小鼠骨退化特异标志物(CTX-2)elisa试剂盒 Mouse CTX-2 ELISA试剂盒96T/48T
小鼠垂体腺苷酸环化酶激活肽(PACAP)elisa试剂盒 Mouse pituitary adenylate cyclase activating polypeptide,PACAP ELISA试剂盒 96T/48T
小鼠血管紧张素转化酶(ACE)elisa试剂盒 Mouse Angiotensin converting enzyme,ACE ELISA试剂盒96T/48T
小鼠血管紧张素Ⅱ(ANG-Ⅱ)elisa试剂盒 Mouse angiotension Ⅱ,ANG-Ⅱ ELISA试剂盒96T/48T
小鼠角化细胞内分泌因子(KAF)/双调蛋白(AR)elisa试剂盒 Mouse keratinocyte autocrine factor/Amphiregulin,KAF/AR ELISA试剂盒96T/48T
小鼠活化素A(ACV-A)elisa试剂盒 Mouse Activin A,ACV-A ELISA试剂盒96T/48T
小鼠脑源性神经营养因子(BDNF)elisa试剂盒 Mouse Brain derived neurotrophic facor,BDNF ELISA试剂盒96T/48T
小鼠骨成型蛋白2(BMP-2)elisa试剂盒 Mouse Bone morphogenetic protein 2,BMP-2 ELISA试剂盒96T/48T
小鼠骨成型蛋白4(BMP-4)elisa试剂盒 Mouse Bone morphogenetic protein 4,BMP-4 ELISA试剂盒96T/48T
小鼠胰岛素样生长因子结合蛋白6(IGFBP-6)elisa试剂盒 Mouse Insulin-like growth factor binding protein 6,IGFBP-6 ELISA试剂盒 96T/48T
小鼠巨噬细胞炎性蛋白1δ(MIP-1δ/CCL15)elisa试剂盒 Mouse Macrophage Inflammatory Protein 1δ,MIP-1δ ELISA试剂盒 96T/48T
小鼠肺部活化调节趋化因子(PARC/CCL18)elisa试剂盒 Mouse pulmonary activation regulated chemokine,PARC ELISA试剂盒96T/48T
小鼠溶菌酶(LZM)elisa试剂盒 Mouse Lysozyme,LZM ELISA试剂盒 96T/48T
小鼠可溶性CD30(sCD30)elisa试剂盒 Mouse soluble cluster of differentiation 30,sCD30 ELISA试剂盒96T/48T
小鼠可溶性肌球蛋白重链2(sMHC-2)elisa试剂盒 Mouse soluble myosin heavy chain 2,sMHC-2 ELISA试剂盒96T/48T
小鼠可溶性肌球蛋白重链1(sMHC-1)elisa试剂盒 Mouse soluble myosin heavy chain 1,sMHC-1 ELISA试剂盒96T/48T
小鼠粘蛋白/粘液素C(MUCC) elisa试剂盒 Mouse Mucin-5 subtype AC,MUCC ELISA试剂盒96T/48T
小鼠血管紧张素转化酶(ACE)elisa试剂盒Mouse Angiotensin converting enzyme,ACE ELISA试剂盒96T/48T
小鼠血管紧张素Ⅱ(ANG-Ⅱ)elisa试剂盒Mouse angiotension Ⅱ,ANG-Ⅱ ELISA试剂盒96T/48T
小鼠角化细胞内分泌因子(KAF)/双调蛋白(AR)elisa试剂盒Mouse keratinocyte autocrine factor/Amphiregulin,KAF/AR ELISA试剂盒96T/48T
小鼠活化素A(ACV-A)elisa试剂盒Mouse Activin A,ACV-A ELISA试剂盒96T/48T
小鼠抗甲状腺过氧化物酶抗体(TPO-Ab)elisa试剂盒 Mouse anti-Thyroid-Peroxidase antibody,TPO-Ab ELISA试剂盒 96T/48T
小鼠脑源性神经营养因子(BDNF)elisa试剂盒Mouse Brain derived neurotrophic facor,BDNF ELISA试剂盒96T/48T
小鼠凋亡诱导因子(AIF)elisa试剂盒 Mouse apoptosis inducing factor,AIF ELISA试剂盒 96T/48T
小鼠骨成型蛋白2(BMP-2)elisa试剂盒Mouse Bone morphogenetic protein 2,BMP-2 ELISA试剂盒96T/48T
小鼠骨成型蛋白4(BMP-4)elisa试剂盒Mouse Bone morphogenetic protein 4,BMP-4 ELISA试剂盒96T/48T
小鼠骨成型蛋白受体1A(BMPR-1A)elisa试剂盒Mouse Bone morphogenetic protein receptor 1A,BMPR-1A ELISA试剂盒96T/48T
小鼠碱性磷酸酶(ALP)elisa试剂盒 Mouse alkaline phosphatase,ALP ELISA试剂盒96T/48T
小鼠血管生成素4(ANG-4)elisa试剂盒 Mouse Angiopoietin 4,ANG-4 ELISA试剂盒96T/48T
小鼠骨成型蛋白受体Ⅱ(BMPR-Ⅱ)elisa试剂盒Mouse Bone morphogenetic protein receptor Ⅱ,BMPR-Ⅱ ELISA试剂盒96T/48T
小鼠主要组织相容性复合体Ⅲ类(MHC-Ⅲ/H-2Ⅲ)elisa试剂盒Mouse major histocompatibility complex-Ⅲ,MHC-Ⅲ/H-2Ⅲ ELISA试剂盒96T/48T
小鼠E钙粘着蛋白/上皮性钙黏附蛋白(E-Cad)elisa试剂盒Mouse E-Cadherin,E-Cad ELISA试剂盒96T/48T
结晶紫中性红胆盐葡萄糖琼脂(VRBDA)售后服务小鼠CD30分子(CD30)elisa试剂盒Mouse Cluster of differentiation 30,CD30 ELISA试剂盒96T/48T
小鼠主要组织相容性复合体Ⅱ类(MHC-Ⅱ/H-2Ⅱelisa试剂盒 Mouse major histocompatibility complex-Ⅱ,MHC-Ⅱ/H-2Ⅱ ELISA试剂盒96T/48T
小鼠可溶性血管内皮细胞蛋白C受体(sEPCR)elisa试剂盒Mouse soluble endothelial protein C receptor,sEPCR ELISA试剂盒96T/48T
小鼠嗜酸粒细胞趋化因子(ECF)elisa试剂盒Mouse eosinophil chemotactic factor,ECF ELISA试剂盒96T/48T
小鼠嗜酸粒细胞趋化蛋白Eotaxin 1(Eotaxin 1/CCL11)elisa试剂盒Mouse Eotaxin 1 ELISA试剂盒96T/48T
小鼠红细胞生成素(EPO)elisa试剂盒Mouse Erythropoietin,EPO ELISA试剂盒96T/48T
小鼠E选择素(E-Selectin/CD62E)elisa试剂盒 Mouse E-Selectin ELISA试剂盒96T/48T
小鼠凋亡相关因子(FAS/CD95)elisa试剂盒Mouse Factor-related Apoptosis,FAS ELISA试剂盒96T/48T